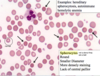

Intro to Anemia Flashcards
What is anemia?
- Anemia is decreased RBC mass. but we can’t measure that so we use hemoglobin concentration of blood as a surrogate
- Decreased O2 carring capacity of blood
- decreased O2 delivery to tissues (final physiologic consequence)

What are the 4 compensatory mechanisms of Anemia?
Increased RBC production
Increased 2,3-DPG (causes right shift)
Shunting of blood from non-vital to vital areas
increased cardic output
Increased pulmonary function
What 3 things cause right shift what 3 things cause left shift?
Right: increased temp, low DPG, low pH
Left: decreased temp, low DPG, high pH

A lot of the symptoms of anemai are caused by the compensatory mechanisms. What mechanisms lead to the following signs/symptoms:
weakness, malaise, easy fatigability
marrow expansion with potnetial bony abnormalities
pallor
tachycardia; cardiac ischemia in severe cases
dyspnea on exertion: increased pulmmonary function
weakness, malaise, easy fatigability: tissue hypoxia
marrow expansion with potnetial bony abnormalities: increased RBC production
pallor: shunting of blood from non-vital to vital areas
tachycardia; cardiac ischemia in severe cases: increased cardiac output
dyspnea on exertion: increased pulmonary function

Explain the disease process of anemia.
TRICK QUESTION!
Anemia is NOT a disease. It is a symptom of other diseases, and all anemias need to be explained
What are the 3 funcitonal classifications of anemai?
Blood loss
Decreased production
Accelerated destruction
What are the 3 morpholigc classifications of anemia?
Microcytic (MCV<80)
Normocytic (MCV=80-100)
Macrocytic (MCV>100)
What arer the two types of microcytic anemia? What are some things that can cause these!
- Normochromatic
- iron-deficiency-early
- thalassemis trait
- (anemia of chronic disease)
- some hemoglobinopathies eg Hemoglobin E
- Hypochromic
- iron deficiency
- thalassemis trait
- siderblastic anemia
- anemia of chronic disease
What are some things that case normochromic/normocytic anemia?
- anemia of chronic disease
- anemia renal failure
- marrow infiltration
- aplastic anemia
- blood loss***
- hemolysis**
What are some things that cause macrocytic anemia?
B12 and folate deficiency
liver disease
myelodysplastic syndromes
blood loss
hemolysis
some drugs
What are the 6 ways that we investigate anemia?
clinical history
physical exam
complete blood count (CBC)
Reticulocyte count
examination of peripheral blood smear
specific diagnostic tests (guided by above)
What things are shown on a CBC?
Hemoglobin concentration
Hematocrit
RBC count
Mean cellular corpuscular volume (MCV)
What does the measure of hemoglobin concentration tell us?
Hemoglobin in lysed sample reactedwith proprietary reagents
resulting complexes measured spectraphometrically
Most important parameter for assesment of O2 carrying capacity
(Hb; g/dL or g/L)
What is the most important parameter for assesment of O2 carrying capacity of blood?
Hemoglobin concentration!
What is the hematocrit?
(Hct; %)
- Packed cell colume (percentage of blood volume comprised by RBCs
- old method was centrifugation
- currentyl calculated as MCV* RBC
- usually 3X hemoglobin- does not add independent information in vast majority of cases (ie we do it for no reason)
What is Red blood cell count?
Direct measure of number of RBCs per unit volume
generally correlated well with Hb and hematocrit, adds little independent information
What is Mean cellular (corpuscular) volume (MCV; fL)
measured directly based on either electrical impedence or light scatter
very useful in the differential diagnosis of anemia (eg microcytic, normocytic, and macrocytic anemias)
What four things lead to a microcytic anemia?
iron deficiency
thalassemis
anemia of chronic disease
other (rare)
What 2 things lead to macrocytic anemia?
Megaloblastic
non-megaloblastic
What is megaloblastic anemia
imparied DNA synthesis
B12 and folate deficiency
some drugs
myelodysplastic syndromes
What is non megaloblastic anemia? What things cause it?
macrocytic anemia not caused by impaired DNA synthesis (Megaloblastic= impaired DNA synthesis)
reticulocytosis
liver disease
hypothyroidism
some drugs
What is mean corspuscular hemoglobin?
(MCH; pg)
calculated as Hb/RBC
measure of averae amoutn of hemoglobin per RBC
high correlation with MCV
What is mean corpuscular hemoglobin concentration?
(MCHC; g/dL)
measure of “chromicity” of RBCs
Calculated as Hb/(MCV*RBC)
decreased in hypochromic anemais
increased in a few “hyperchromic” states (eg. hereditary spherocytosis, hemoglobin CC disease)